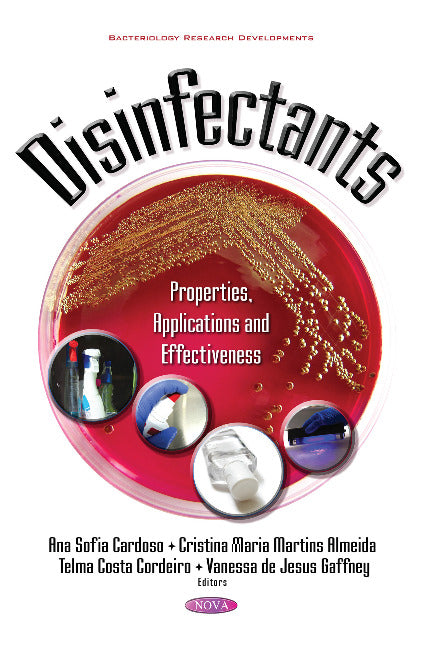
Disinfectants

Antiseptics and disinfectants are extensively used at home, in occupied buildings, recreational areas, industries (the water industry, food processing industry and pharmaceutical industry, among others), hospitals and other healthcare settings for a variety of topical and hard-surface applications. They play a critical role in controlling the spread of environmentally transmitted pathogens in healthcare and food-processing environments, as well as at home. A wide variety of active chemical agents are found in these products, many of which have been used for hundreds of years for antisepsis, disinfection, and preservation. Although its main purpose is to control human exposure to microorganisms through preventive action, its use should also be carefully controlled in order to prevent healthcare problems that may consequently emerge due to their toxicity. The problems regarding the use of disinfectants are not new, although unquestionably tangible and pertinent, due to its broad application in the referred economical activities, as well as due to the development and emerging of new compounds with this activity. This book aims to address the various scenarios regarding the use of disinfectants. Accordingly, through its eleven chapters it is possible to become aware of the wide range of disinfectant applications, as well as the concerning advantages and limitations of its use. This book is divided into two main sections. The first section, after an overview regarding the use of disinfectants in society, addresses questions related to its toxicology and health repercussions along with microbiological mechanisms. In the second section, a far-reaching exploration of the application of disinfectants in a set of specifically selected economic activities, alongside issues concerning their environmental impact and regulatory matters is addressed. This section also includes two case studies on novel disinfection methods.
Cristina Ameida was born in Barreiro, Portugal, in 1965. She received her Ph.D. in Chemistry and Microbiology of Water in 2001. She has over twenty-five years of experience of university teaching in graduate or postgraduate studies of Faculty of Pharmacy of the University of Lisbon (FFUL). Her teaching experience is focused in water and food quality. Since June 1992, she he has served as consultant for Technical Directorate in an accredited water laboratory, and she is responsible for the implementation and validation of several analytical methods for the analysis of sensory and physicochemical parameters of water quality, the validation of sampling protocols and storage of the samples accordingly national and international procedures. She has published several scientific papers in scientific journals and she is the author of a few book chapters. Other relevant activities include the following: coordinates and manages the water laboratory of FFUL, member of the Portuguese Pharmacopoeia Committee, partner of Portuguese and European projects related with water quality and supervising or co-supervising master and doctorate students. Cristina Almeida's scientific focus is on method development and monitoring of priority, new and emerging pollutants in water, including endocrine disrupting compounds and pharmaceutical active compounds, using advanced mass spectrometric analysis such as LC-MS/MS combined with several sample preparation techniques, mainly solid phase extraction.